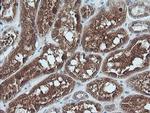
UBE2G2 Antibody in Immunohistochemistry (Paraffin) (IHC (P))

Search
OriGene
UBE2G2 Monoclonal Antibody (OTI1D7), TrueMAB™
{{$productOrderCtrl.translations['antibody.pdp.commerceCard.promotion.promotions']}}
{{$productOrderCtrl.translations['antibody.pdp.commerceCard.promotion.viewpromo']}}
{{$productOrderCtrl.translations['antibody.pdp.commerceCard.promotion.promocode']}}: {{promo.promoCode}} {{promo.promoTitle}} {{promo.promoDescription}}. {{$productOrderCtrl.translations['antibody.pdp.commerceCard.promotion.learnmore']}}
产品信息
CF505258
种属反应
宿主/亚型
分类
类型
克隆号
抗原
偶联物
形式
浓度
纯化类型
保存液
内含物
保存条件
运输条件
产品详细信息
For reconstitution, we recommend adding 100 µL distilled water to a final antibody concentration of about 1 mg/mL. To use this carrier-free antibody for conjugation experiments, we strongly recommend performing another round of desalting. (Zeba Spin Desalting Columns, 7KMWCO, 0.5 mL, Product # 89882)
靶标信息
The modification of proteins with ubiquitin is an important cellular mechanism for targeting abnormal or short-lived proteins for degradation. Ubiquitination involves at least three classes of enzymes: ubiquitin-activating enzymes, or E1s, ubiquitin-conjugating enzymes, or E2s, and ubiquitin-protein ligases, or E3s. This gene encodes a member of the E2 ubiquitin-conjugating enzyme family. The encoded protein shares 100% sequence identity with the mouse counterpart. This gene is ubiquitously expressed, with high expression seen in adult muscle. Three alternatively spliced transcript variants encoding distinct isoforms have been found for this gene.
仅用于科研。不用于诊断过程。未经明确授权不得转售。
篇参考文献 (0)
生物信息学
蛋白别名: E2 ubiquitin-conjugating enzyme G2; Ubiquitin carrier protein G2; ubiquitin conjugating enzyme 7; ubiquitin conjugating enzyme E2G 2; ubiquitin conjugating enzyme G2; ubiquitin-conjugating enzyme 7 homolog; Ubiquitin-conjugating enzyme E2 G2; ubiquitin-conjugating enzyme E2G 2 (homologous to yeast UBC7); ubiquitin-conjugating enzyme E2G 2 (UBC7 homolog, yeast); Ubiquitin-protein ligase G2
基因别名: 1110003O05Rik; D10Xrf369; UBC7; Ubc7p; UBE2G2
UniProt ID: (Human) P60604, (Mouse) P60605
Entrez Gene ID: (Human) 7327, (Dog) 611581, (Mouse) 22213